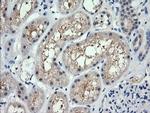
RARRES1 Antibody in Immunohistochemistry (Paraffin) (IHC (P))

Search
OriGene
RARRES1 Monoclonal Antibody (OTI1B1), TrueMAB™
{{$productOrderCtrl.translations['antibody.pdp.commerceCard.promotion.promotions']}}
{{$productOrderCtrl.translations['antibody.pdp.commerceCard.promotion.viewpromo']}}
{{$productOrderCtrl.translations['antibody.pdp.commerceCard.promotion.promocode']}}: {{promo.promoCode}} {{promo.promoTitle}} {{promo.promoDescription}}. {{$productOrderCtrl.translations['antibody.pdp.commerceCard.promotion.learnmore']}}
产品信息
TA506084
种属反应
宿主/亚型
分类
类型
克隆号
抗原
偶联物
形式
浓度
规格
纯化类型
保存液
内含物
保存条件
运输条件
靶标信息
This gene was identified as a retinoid acid (RA) receptor-responsive gene. It encodes a type 1 membrane protein. The expression of this gene is upregulated by tazarotene as well as by retinoic acid receptors. The expression of this gene is found to be downregulated in prostate cancer, which is caused by the methylation of its promoter and CpG island. Alternatively spliced transcript variant encoding distinct isoforms have been observed.
仅用于科研。不用于诊断过程。未经明确授权不得转售。
篇参考文献 (0)
生物信息学
蛋白别名: latexin-like; PERG-1; Phorbol ester-induced gene 1 protein; RAR-responsive protein TIG1; retinoic acid receptor responder (tazarotene induced) 1; Retinoic acid receptor responder protein 1; Tazarotene-induced gene 1 protein; TIG1
基因别名: LXNL; PEIG1; PERG-1; RARRES1; TIG1
UniProt ID: (Human) P49788
Entrez Gene ID: (Human) 5918